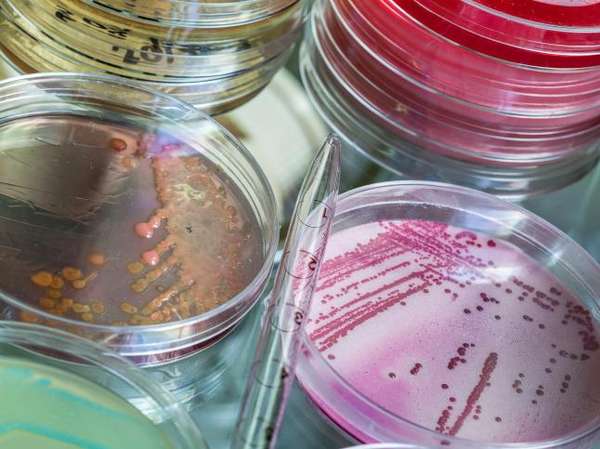

Dear Beloved,
My sincere greetings to you, Please permit me to introduce myself, My name is Ainfa Justin Yak, 24years old female (single) originated from Sudan. I appeal to you to exercise a little patience and read through my letter although, we have neither met in person but I decided to contact you personally for a long term business Relationship and investment assistance in your country.
My father Dr. Justin Yak Arop was the former Minister for SPLA Affairs and Special Adviser to President Salva Kiir of South Sudan for Decentralization. My father Dr. Justin Yak and my mother including other top Military officers and top government officials had been on board when the plane crashed on Friday May 02, 2008. My late Father Dr. Justin Yak was an investor, he invested his fund to stock exchange market, Gold storing investment, he was a preference shareholder in Shell Petroleum Company and deals in Real Estate building investment.
I have chosen to contact you after my prayers and I believe that you will not betray my trust. But rather take me as your own sister. Though you may wonder why I am so soon revealing myself to you without knowing you, well, I will say that my mind convinced me that you are the true person to help me. I want you to stand as my trustee and clear my inheritance fund to your Bank account for investment purpose while I will spend the rest of my life with you after the transfer.
More so, I will like to disclose much to you if you can help me to relocate to your country because my uncle has threatened to assassinate me. The amount is $6.5 Million and I have confirmed from the bank. You will also help me to place the money in a more profitable business venture in your Country. However, you will help me by recommending a nice University in your country so that I can complete my studies. It is my intention to compensate you with 25% of the total money for your services while 5% will be for any expense that may occur during the process and the balance shall be my capital in your establishment.
I have no knowledge of international transaction of this nature but it occurred to me that transfer of this type must involve expenditure. As soon as I receive your interest in helping me, I will put things into action immediately. In the light of the above, I shall appreciate an urgent message indicating your ability and willingness to handle this transaction sincerely by replying to me, Please do keep this only to your self, I beg you not to disclose it till i come over because I am afraid of my wicked uncle who has threatened to kill me.
Sincerely yours Ainfa Justin Yak.
Sorry if you received this letter in your spam, Due to recent
connection error here in the country